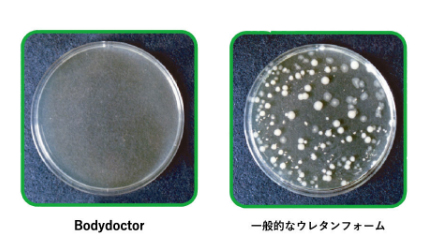

仕様情報
既製品とは異なるオリジナリティーを追求したシートカバー。
素材から縫製まで全てを国内生産とするセミオーダーシステムを採用。
ダイヤ/スクエア/ストライプの3タイプから選べるスタイルは
素材と色の組み合わせで約8000通り以上のパーターンで
お客様の理想のスタイルへと導きます。
ドレスアップ性を高めるだけでなく、
素材にも拘り車内を上質な空間と快適な乗り心地を与えます。
仕様情報

■SSPU(スーパーソフトポリウレタンレザー)【難燃加工】シンコール社製
|
|
※2021年1月よりブラウンの仕様変更あり(以前の仕様より色味が濃くなっております)
※画像は撮影環境及びPC等のモニター環境により実際のカラーとは異なる場合がございます。
画像クリックで拡大表示
素材特徴
一般的によく使用されているPVCよりサラサラとした柔らかい肌触りと質感で吸湿&通気性に優れた高級ポリウレタンレザー。
ホテル等に採用されている環境に配慮したポリウレタンレザーのスーパーソフトレザーを
ベースに自動車用にオリジナルで加工した人工皮革。

SSPU:【シンコール社製】
■耐光(高温)/100hr 変退色(級)4~5
■摩擦Ⅱ形(10往復) 乾:5級/湿 5級/(100往復)乾:5級
■燃焼性試験/自消性
PUレザーと、PVCレザーの比較
| SSPUと一般的なPVCとの比較 | 肌触り | 吸湿・通気性 | 皮革柔軟性 | フィッティング | 素材コスト | 匂い |
| SSPUレザー(スーパーソフトポリウレタン) | さらさら | ○ | 柔らかい | ○ | 高価 | 無臭 |
| 一般的なPVC素材(ポリ塩化ビニール) | ベタベタ | × | 硬い | × | 安価 | ビニール臭 |
PU(ポリウレタン樹脂)レザーの特徴 |
||||||
|
PUとは、「Polyurethane (ポリウレタン)」の略です。 柔らかくしなやかで、肌の様な風合いがあり、より本革(天然皮革)に近い質感があります。疑似本革と しては、 最高級にあたります。弾力性、柔軟性が高く、やわらかいカーブがポイントのソファ等に適しています。 PVCレザーに比べると通気性があり、撥水性も高いのでメンテナンスが非常に簡単です。 PVCレザーよりは経年劣化はしにくいですが、本革に比べると耐久性は劣ります。 |
PVC(塩化ビニル樹脂)の特徴 |
||||||
|
PVCとは、「Polyvinyl chloride (ポリビニールクロライド)」の略です。 耐久性が高く、汚れに強いので、水や中性洗剤で汚れを拭く事ができる為メンテナンスが非常に簡単です。 加工性が高く、機能性(防汚、抗菌等)の高い付加価値商品があります。PVCレザーは比較的安価に手に 入れる事ができますが、通気性や弾力性、柔軟性では、PUレザーには劣ります。また、長年の使用で、 表面が固くなったり、経年劣化で表面のコーティングが割れるリスクがあります。 表面がつるつるしているので滑りやすい、通気性が低いため湿度の高い季節は汗でべたべたする点は、以外と見落としやすい点です。 |
お手入れ方法 |
||||||
|
|
||||||
|
空拭き及び本革クリーナー(合成皮革対応)をご使用下さい。
汚れを落とす為に水拭きをする場合は空拭きで十分に水分を拭き取り乾燥を十分にしてください。
デリケートな素材で扱いが難しそうに感じられますが、基本的な日常ののお手入れはほぼメンテナンスフリー となるのがPUレザーのメリットでもあります。 素材の特性を知る事で長くご愛用していただく事ができます。 |
■生地価格表
SSPU(100cm×125cm)
|
||||
|
(メーター単価/5mmウレタンフォーム付) |
||||
|
|
||||
|
※生地はパンチング加工無しとなります。 ※300㎝までロール対応可能 |

■ラムース/Lamous(高級スウェード調レザー)旭化成社製
|
ラムース:【旭化成社製】
■耐光(高温)/100hr 変退色(級)4~5
■摩擦Ⅱ形(10往復) 乾:5級/湿 5級/(100往復)乾:5級
■燃焼性試験(難燃性)/自消性/制電性能
|
|
|
※画像は撮影環境及びPC等のモニター環境により実際のカラーとは異なる場合がございます。
画像クリックで拡大表示
素材特徴
|
「ラムース」とは、超極細繊維による、高級スエードのようなソフトでなめらかな触り心地に加え、強さとしなやかさ、軽さ、通気性、保湿性などをあわせもつ高級スエード調人工皮革です。レザー特有の冬は冷たく、夏は蒸れるといったことがなくいつでも快適なカーライフを与えてくれます。 ラムースの特徴は、なんと言っても“汚れに強い”ところ。液体をこぼしても水玉状になるので、乾いた布で吸い取るように押さえれば、しこみまずに簡単に拭き取れます。“ひっかき”によるキズやほつれにも強いので、ずっと使い続けることを考えれば、この素材の強さは注目すべき点でしょう。 また、ラムースの構造は非常に細かく、ダニすら内部に通さないほど。いつも清潔に保つことができます。3歳以下の乳幼児にも優しい素材です。 |
■ソフトな手触り
緻密に絡み合った超極細繊維がなめらかなタッチを生み出し、デザイナーの感性を触発します。
■軽くて強い
本革より軽く、内部にある特殊織物(スクリム)が優れた強度を与えています。
■環境と人に優しい素材
一部にリサイクル原料を使用した超極細繊維を選び、人工皮革業界でいち早く水系ポリウレタン
の使用を進めています。欧州Reach規制等の化学物質取扱い基準に沿った製品管理を行い、
環境と人への影響に配慮した取り組みを進めています。
エコテックス・スタンダード100認証を取得しており、3歳以下の乳幼児向けにも優しい素材です。
■安定した品質
独自製法で厚みの均一性を可能にし、内部の特殊織物(スクリム)により品質バラつきが少なく
加工しやすい素材です。ISO9001の認証を受けた日本の工場で生産し品質管理を徹底しています。
こだわりの品質ラムース
3歳未満の乳幼児製品にも使用できる規格に合格しています。

| エコテックス100規格 | |||
| 繊維製品の安全性を認証する世界的な規格、エコテックス100規格の認証を取得するなど、人体に害を与える有害物質を含まない人に優しい素材です。 |
|

お手入れ方法 |
||||||
|
|
||||||
ー 日頃のお手入れ ー普段のお手入れは、衣料用ブラシを軽くかけるだけで結構です。また、ぬるま湯に浸して固く絞った布で、定期的に全体を拭くことをおすすめします。ラムースは初期撥水加工を施されている人工スエード調皮革になります。
ー 部分的な汚れの落とし方 ー汚れはすぐに拭きとるようにしてください。 水性の汚れ中性洗剤を溶かしたぬるま湯を布に含ませて、汚れた部分を軽くたたくようにして拭き取り、その後湿らせた布で洗剤を十分に拭き取ってください。 油性の汚れまず上記と同様の方法をお試しください。それでも汚れが残るようであれば、アルコールを布に含ませて、汚れた部分をたたくようにして拭き取ってください。
|
■生地価格表
ラムース(100cm×125cm)
|
||||
|
(メーター単価/5mmウレタンフォーム付) |
||||
|
※生地はパンチング加工無しとなります。 ※300㎝までロール対応可能 |
■アクセントステッチカラー:全17色
※画像は撮影環境及びPC等のモニター環境により実際のカラーとは異なる場合がございます。 画像クリックで拡大表示
|
ボディードクターとは?
 |
 |
|
ボディドクターの素材は、一般的なウレタンとは一線を画する100%ヴァージンラテックスフォーム(天然発砲ゴム)です。厳選した裁量のゴムの木から抽出した最上質の天然ラテックスだけを使用。純度の高い天然ゴムを発砲させ、微小な気泡が均一なものしか使用しません。この独自の空気層を持つ多孔構造によって湿気を速やかに喚起し、通気性を確保します。 |
|
|
ソフトでハード、柔らかく硬い正反発®による効果で理想的な姿勢を維持
|
|||
|
シートパッド/ウエストパッド採用されているラテックスフォーム
痛みの原因を科学した ボディドクターで「腰」を護る!
 |
またボディドクターに使用されている高反発天然ラテックスフォームの最大の特徴は、人体の表面硬度に近い柔らかすぎず硬すぎない特有の弾力性を持った柔らかさと弾性の同居にあります。ラテックスマットは発砲時に、多数の気泡を作ることで、さらにソフトな柔らかさを実現し、同時に高い反発力も維持しています。この柔らかさが体の凸部を優しく吸収し、高い反発力が体の凹部をしっかり支えてくれ抜群の体圧分散機能を発揮します。 |
細菌を99.9%天然殺菌するボディドクターのラテックスフォーム
|
ボディドクターの高品質ヴァージンラテックスフォームは 高いレベルの抗菌活性や抗カビ活性を持つことで、いやなニオイを抑え、ダニなどの虫も付きにくいといった効果も検証されています |
|
| (財)日本紡績検査協会でのテストでも、一般性細菌の大腸菌、黄色ブドウ球菌、連鎖球菌や雑菌などを24時間以内に天然殺菌することを実証。人体に悪影響を及ぼす心配がないので安全です。 | ||
介護用品としても使用されています。
床ずれ予防として高い評価を得ているボディドクターでは、全国の病院や医療機関で採用されています。
|
ボディードクターと他社製品マットの違い
|
||
|
石油製品では出せない独特の柔らかさと反発力が特有で、ベッド先進国であるヨーロッパでは100年以上も前に開発され、今なお愛され続ける素材です。ボディドクターのラテックスフォームはマレーシアのゴム農園で育成されたゴムの木からゴム樹液を抽出し、さらに何層ものフィルターでろ過し、コンピュータ管理のもとでキメ細かさを均一にそろえながら発泡させ、最後は熟練した職人の手で一枚一枚作られています。マレーシアでは、防腐剤として毒性があるホルムアルデヒドの使用を国が法律で規制しており、ボディドクターも厳しい品質管理の中で生み出されています。 |
世界の評価機関から高い評価を認められた優れた品質
ボディドクターは、ヨーロッパの権威ある研究機関LGAの耐久テストにおいて、高得点を獲得しました。
さらに基準の厳しいベッドマットレス基準ECOLABELもいち早く取得しました。
そのすぐれた品質は、安全性、品質、環境性能など、あらゆる角度から国際的に高く評価されています。
|
◎LGA(ドイツ効率検査テスト機関) ◎ISPA(国際寝具協会認定) ◎NATURAL LATEX(天然ラテックス使用) ◎BETTER SLEEP COUNCIL(アメリカ優良寝具評議会認定) ◎ECOLABEL(ドイツベットマットレス基準) ◎日本医学交流協会医療団 |
|
|
|
|||||||||
|
|
|||||||||




























































